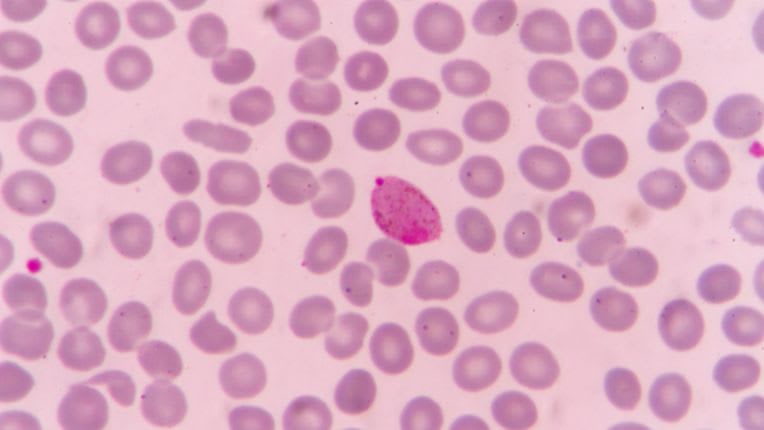
Image au microscope du parasite plasmodium, cause du paludisme.

Paludisme
La maladie : le paludisme
Le paludisme est une maladie redoutable qui touche principalement les zones tropicales et subtropicales. Il est présent dans près de 100 pays et cause chaque année la mort de près de 600 000 personnes dans le monde, selon l'OMS, en grande partie des enfants d'Afrique Sub-Saharienne.
10 000 voyageurs
En France, l'incidence du paludisme concerne environ 10 000 voyageurs (selon l'Institut Pasteur) qui peuvent être infectés lors de leurs déplacements en zones à risque, souvent leur pays d'origine en Afrique de l'Ouest. Les voyageurs résidant dans des régions exemptes de paludisme sont exposés à un risque accru de contracter cette maladie.
⚠️ Attention : une fièvre survenant chez un voyageur dans les 7 jours suivant son arrivée en zone à risque, jusqu'à 3 mois après son départ, constitue une urgence médicale qui doit être prise en charge immédiatement.
💡 Bon à savoir : malheureusement, il n'y a pas actuellement de vaccin contre le paludisme adapté aux voyageurs. Néanmoins, il existe un programme de vaccins antipaludiques suivi par l'OMS. Appelés RTS,S/AS01 et R21/Matrix-M, ils sont réservés à la prévention de P. falciparum chez les enfants qui vivent dans des zones touchées par une transmission modérée ou élevée.
Les causes du paludisme : une piqûre de moustique et un parasite
Plasmodium
Le paludisme est causé par un parasite du genre Plasmodium. Quatre principales espèces différentes peuvent infecter l’être humain :
-
P. falciparum (le plus dangereux),
-
P. malariae,
-
P. ovale,
-
P. vivax.
L’homme peut occasionnellement être infecté par des espèces de Plasmodium qui parasitent normalement les animaux, notamment le plasmodium knowlesi, qui devient de plus en plus fréquent dans certaines régions d’Asie et, notamment, en Malaisie.
Transmission : Pourquoi le paludisme est une maladie vectorielle ?
Le parasite du paludisme est transmis par des moustiques femelles de l’espèce Anophèles, qui piquent surtout entre le coucher et le lever du soleil (sauf knowlesi). La protection contre les moustiques doit donc être renforcée la nuit.
Comment prévenir le paludisme
La chimio prophylaxie (prévention par des médicaments)
- Il est nécessaire de consulter avant le départ car les médicaments préventifs du paludisme doivent être prescrits par un médecin : Une consultation n’aboutit pas toujours à une prescription de traitement, mais un personnel qualifié peut vous donner des informations précieuses pour votre voyage.
- Éviter les piqûres de moustiques : C’est la première ligne de défense contre la maladie.
Traitement médical préventif (chimioprophylaxie) : Les médicaments doivent être adaptés au risque réel de contracter le paludisme dans les régions visitées et au groupe de résistance dans lequel le pays est classé.
Les médicaments proposés contre le paludisme
Antipaludéens
-
atovaquone-proguanil (Malarone®). Il convient de le prendre la veille du départ et de continuer durant sept jours après le retour.
-
doxycycline (Vibramycine®, Vibra-Tabs®, Doxypalu®). Elle doit être utilisée la veille du départ et pendant les quatre semaines qui suivent le jour où l'on a quitté la zone d'endémie.
-
méfloquine (Lariam®). Il faut commencer le traitement une ou deux semaines avant le départ pour s'assurer de sa bonne tolérance. Elle doit être prise, une fois par semaine, puis, pendant trois semaines, après avoir quitté la zone impaludée.
Prescription médicale
Ces traitements sont soumis à prescription médicale : c’est le médecin en cabinet ou en Centre de vaccination Internationale qui évaluera la nécessité de le prendre, délivrera l’ordonnance et fera ses recommandations.
-
Prise en charge rapide en cas de fièvre : En cas de fièvre pendant ou au retour du voyage, il est nécessaire de consulter rapidement un médecin et de l’informer du voyage pour éviter tout risque de mortalité.
Symptômes de la maladie
Les symptômes initiaux du paludisme peuvent être bénins et comprennent généralement :
-
fièvre,
-
maux de tête,
-
frissons,
-
douleurs musculaires,
-
fatigue,
-
vomissements,
-
diarrhées,
-
toux,
-
douleurs abdominales.
Crise de paludisme
Sans un traitement rapide, la maladie peut évoluer en une forme grave impliquant une défaillance polyviscérale ou neurologique, pouvant entraîner la mort du ou de la patiente.
Mortel
Le paludisme peut être mortel si le traitement n'est pas commencé dans les 24 heures suivant l'apparition des premiers symptômes. Même après la disparition des symptômes, le parasite peut rester latent dans les cellules hépatiques et provoquer des rechutes à des moments ultérieurs.
Auteur
Article écrit le 02/05/2023
Modifié le 23/12/2025, vérifié par Pierre Luton, journaliste expert en santé, social et référencement SEO (E-E-A-T)
Vos questions fréquemment posées sur le paludisme, son traitement et sa prévention:
C'est quoi le palu (ou paludisme, ou malaria) ?
Le terme "palu" est souvent utilisé pour désigner le paludisme, une maladie qui peut être transmise par un moustique. Bien que l'on soit parvenu, à ce stade, à l'élimination du paludisme en Europe, celui-ci a causé des épidémies graves par le passé. Aujourd'hui, le paludisme reste une catastrophe mondiale principalement en Afrique sub-saharienne, en Asie du Sud-Est, en Amérique centrale et en Amérique du Sud. La transmission de la maladie se produit lorsqu'un moustique pique une personne infectée, puis transmet le parasite à une autre personne. Le parasite se multiplie dans les globules rouges, causant finalement leur éclatement et des poussées de fièvre. Il est conseillé aux voyageurs d'évaluer leur risque avec un professionnel de santé compétent en médecine des voyages.
Comment attrape-t-on le paludisme ?
Le paludisme se propage à travers la transmission du parasite par les piqûres de moustiques infectés. Lorsque le moustique pique une personne atteinte de paludisme, il absorbe des parasites avec le sang. Ensuite, lorsqu'il pique une autre personne, il transmet les parasites à travers sa salive, causant l'infection chez la personne piquée. Le paludisme est une maladie qui existe depuis des siècles et qui continue à affecter les populations dans de nombreuses régions du monde.
Quelles sont les conséquences du paludisme ?
Le paludisme a des conséquences graves pour les individus et les communautés. Pour les personnes infectées, les symptômes peuvent aller de la fièvre à la mort. Les enfants sont les plus vulnérables dans les régions endémiques car l'immunité au paludisme est difficile à construire et ne dure que 18 mois maximum. Les adultes, exposés à des contaminations répétées, développent finalement une immunité relative, mais perdent celle-ci s'ils quittent le pays pendant plusieurs années. La lutte contre le paludisme est une priorité pour l'Organisation mondiale de la santé (OMS) et les pays affectés.
Comment guérit-on du paludisme ?
Le paludisme peut être guéri facilement avec un traitement adéquat pris au début de la crise. Cependant, le parasite devient de plus en plus résistant aux médicaments utilisés pour le combattre, ce qui rend la course pour la découverte de nouveaux traitements encore plus importante. Si une crise de paludisme n'est pas traitée à temps, elle peut évoluer vers une forme grave et potentiellement mortelle. Bien que des traitements efficaces existent pour la crise, éliminer complètement le parasite peut être difficile, car il peut rester dans les cellules hépatiques. Cependant, après quelques semaines à un maximum de quelques mois, il n'y a plus de danger de mort.
Quels sont les symptômes de la maladie du paludisme ?
Si vous avez de la fièvre lors de vos séjours ou au retour de pays où sévit le paludisme, il est important de consulter un médecin car c'est le signe le plus constant de la maladie. Si un diagnostic rapide n'est pas possible, il est préférable de prendre un traitement contre la crise pour éviter une évolution vers un accès pernicieux potentiellement mortel. Il existe un test diagnostique rapide, fiable et généralement disponible dans les pays touchés par le paludisme, qui ne nécessite qu'un petit échantillon de sang prélevé au bout du doigt.
Le paludisme peut s'apparenter à une grippe ou à des problèmes abdominaux avec des maux de ventre et des troubles du transit. Il est donc important de consulter en cas de fièvre et de mentionner si vous revenez des tropiques pour rechercher un paludisme. Toute crise de paludisme peut être dangereuse et il est important de la prendre au sérieux.
Au retour d'une zone impaludée : une fièvre est un paludisme jusqu'à preuve du contraire.
Peut-on guérir du paludisme ?
Le traitement pour la crise de paludisme est efficace, à condition que le diagnostic soit fait rapidement. Cependant, le parasite peut rester dans le corps de la personne infectée, causant des rechutes plusieurs mois ou années plus tard. Le parasite peut rester en sommeil dans les cellules hépatiques. Le parasite Plasmodium falciparum le plus dangereux ne cause des crises à distance que quelques semaines, exceptionnellement des mois, après l'infection, tandis que les autres espèces peuvent causer des rechutes à distance mais sans danger de mortalité.
Quel moustique transmet le paludisme ?
Les moustiques anophèles sont les principaux vecteurs du paludisme et peuvent propager la maladie en transmettant le parasite Plasmodium à travers leur salive lorsqu'ils piquent. Dormir sous une moustiquaire imprégnée d'insecticide est un moyen de prévention efficace pour réduire le risque d'exposition au parasite. Il est important de noter que les anophèles peuvent également être présents en Europe, mais ils ne sont pas actuellement porteurs du parasite Plasmodium.
Traitement préventif contre le paludisme : combien de temps avant ?
La décision de commencer un traitement préventif contre le paludisme est basée sur le médicament prescrit par le médecin. Le médicament le plus souvent prescrit est la combinaison d'atovaquone-proguanil, connue sous le nom de Malarone, qui doit être commencée la veille du départ et continuée pendant sept jours après le retour. D'autres médicaments tels que la doxycycline peuvent également être prescrits, en commençant la veille du départ et en continuant pendant quatre semaines après avoir quitté la zone d'endémie palustre. Le Lariam® (méfloquine), doit être commencé une ou deux semaines avant le départ pour s'assurer de sa bonne tolérance, et doit être pris une fois par semaine et pendant trois semaines, après avoir quitté la zone impaludée.
Quand a lieu la journée mondiale contre le paludisme en 2025 ?
La journée mondiale contre le paludisme a lieu, tous ans, le 25 avril. Cette journée, précise l'Organisation mondiale de la santé (OMS) a été créée en 2007 par les états membres de l' OMS.
Vaccin contre le paludisme ?
Il n'existe pas de vaccin contre le paludisme pour les voyageurs mais des traitements que l'on peut prendre, selon les cas, avant de partir en voyage. Adressez-vous à l'un des centres de vaccination internationale (CVI) d'Elsan en France.
Deux vaccins antipaludiques, RTS,S/AS01 et R21/Matrix-M, sont actuellement destinés aux enfants dans des zones touchées, notamment en Afrique (Ghana, Kenya, Malawi).

